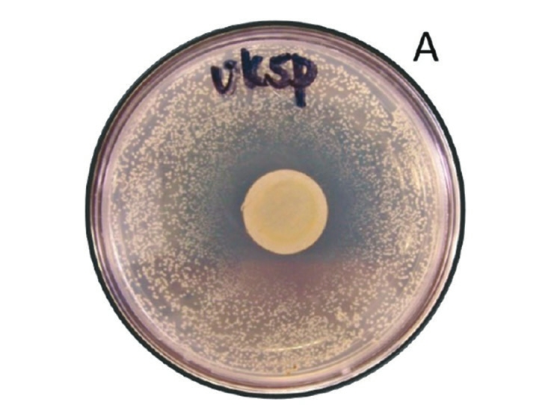

Грязные деньги: кто живет на монетах и банкнотах
Бабушка всегда заставляла меня мыть руки после того, как я трогал деньги. Она была права: первые опасения, что бумажные деньги могут служить переносчиками патогенов, появились более ста лет назад [Schaarschmidt 1884], а первое систематическое исследование — чуть менее пятидесяти [Abrams 1972], когда мне было девять лет. (Не думаю, впрочем, что бабушка была знакома с этими публикациями, — скорее, ею двигал простой здравый смысл и, возможно, влияние дедушки-хирурга.)
Ранние работы опирались на классические микробиологические подходы и могли оценить распространенность только культивируемых бактерий. Сразу стало ясно, — впрочем, как и ожидалось, — что на монетах бактерий меньше (13%), чем на бумажных деньгах (42%). Это подтвердилось в Камеруне, где бактерии были найдены на 97% банкнот и 88% монет, и в Польше: 80–90% и 65% соответственно.
Высокий уровень зараженности бумажных денег наблюдали как в США — патогенные бактерии на 95% долларовых банкнот в западном Огайо, так и в странах третьего мира — до 100% купюр в Гане, Бангладеш, Индии и Иране. Тем не менее степень зараженности бумажных денег коррелирует с экономическими индикаторами, сильнее всего — с «индексом экономической свободы»: чем он выше, тем деньги чище (рис. 1).



Рис. 2. Электронная микрофотография поверхности бумажной [британские 10 фунтов стерлингов, www.catalogofmoney.com] и ластиковой [авcтралийские 10 долларов, 33tura.ru] банкноты. Линия показывает масштаб 50 микрон [Vriesekoop 2010]


Рис. 3. Грибки на нигерийских банкнотах [100 найра, www.mcoin.ru]: почти на всех есть Aspergillus flavis и Candida albicans [Okinbowa 2010]
Больше микроорганизмов находят на купюрах низких номиналов — это наблюдали в Индии, Пакистане, Египте, Танзании, Польше, Иране, Камеруне, Эфиопии. В этом тоже нет ничего неожиданного; впрочем, это не так в Мьянме и Бразилии. Старые банкноты сильнее заражены, чем новые, а на свежеотчеканенных монетах бактерий нет.
Менее тривиальным является наблюдение, что на деньгах существенно чаще встречаются Грам-положительные бактерии, особенно спорообразующие Bacillus spp. и стафилококки, чем Грам-отрицательные. Ясно, что споры живучи; что до остальных, то, возможно, дело в том, что клеточная стенка предохраняет от высыхания. Впрочем, на мексиканских банкнотах в 20 песо самой распространенной бактерией была Грам-отрицательная Burkholderia cepacia, на иранских риалах — Escherichia coli, а на бразильских риалах — протеобактерии и лишь затем фирмикуты.
Поскольку исследователей интересовала в первую очередь эпидемиологическая опасность, банкноты для анализа часто собирали на рынках и в заведениях общепита. В Рангуне (Мьянма) самая большая зараженность бактериями наблюдалась во время влажного жаркого сезона. В Нигерии самыми грязными были деньги, которыми расплачивались мясники и нищие; в Кении — монеты мясников. В Камеруне самыми зараженными оказались купюры, полученные у мясников и пациентов больниц. В то же время в Эфиопии одинаковая зараженность кишечной палочкой наблюдалась у денег мясников, молочников и продавцов овощей и фруктов.
Бактерии попадают на банкноты не только с рук, но и с других, загрязненных банкнот. В контролируемом эксперименте исследователи из Химико-биологического центра Армии США показали, что за сутки при контакте банкнот друг с другом заражаются 5% новых долларовых банкнот, за трое суток — 9%, а при потирании — 24%. Стафилококки, кишечные палочки и энтерококки лучше всего выживают на румынских леях; видимо, это связано со строением бумаги, из которой они изготовлены.
На американских монетах кишечные палочки держатся дольше, чем сальмонеллы (7–11 и 1–9 дней соответственно), причем это время растет от одноцентовых монет (медь) к пятицентовым (75% меди, 25% никеля) и к десятицентовым (медная сердцевина, покрытая медно-никелевым сплавом). Заметим, однако, что состав поверхности пятицентовых никелей и десятицентовых даймов совпадает, и пока не ясно, чем вызваны наблюдаемые различия.
В опытах с ирландскими монетами в 1 пенни (сталь, покрытая медью) было показано, что именно высыхание, а не медь является лимитирующим фактором для стафилококков. В то же время на двуевровых монетах в той же Ирландии стафилококки живут долго, до двух месяцев. Многие монеты подавляют рост бактерий на чашке Петри, причем степень подавления зависит и от вида бактерии, и от состава монетного сплава (рис. 4).

Рис. 4. Подавление роста стафилококков монетами из различных сплавов [en.numista.com, Vriesekoop 2016]. (А) На чашке Петри лежала британская монета в 5 пенсов (75% Cu, 25% Ni), след от которой виден в центре. (В) Размер зоны подавления (в зависимости от времени) для монет в 1 цент (Нидерланды, бронза, квадраты), 20 центов (Австралия, 75% Cu, 25% Ni, черные кружки) и 1 доллар (Австралия, 92% Cu, 6% Al, 2% Ni, белые кружки)
В частности, стафилококки и Cronobacter sakazakii чувствительны к содержанию никеля в медно-никелевых монетах. При этом опыты с бактериями, которые перед помещением на монеты росли на среде в присутствии металлов, показывают, что бактерии могут приспособиться к существованию на поверхности монет: предварительное знакомство с металлом улучшает выживаемость на монете.


Рис. 5. На бразильских банкнотах [1 риал, catawiki.com] обнаружены представители 3310 родов бактерий [Pereira da Fonseca 2015]. Внутренний круг — филумы, внешний круг — семейства
Современные методы анализа микробиомов, основанные на секвенировании и не зависящие от культивирования, показывают куда большее разнообразие бактерий на банкнотах. На бразильских риалах были найдены представители 3310 родов и 1193 семейств, при этом разнообразие не зависело от номинала банкноты. Самыми частыми были стафилококки, Moraxellaceae, Enterobacteriaceae и Acinetobacter spp. (рис. 5). На индийских банкнотах в 10, 20 и 100 рупий также было найдено большое разнообразие микроорганизмов, причем больше всего — на купюрах в 100 рупий (рис. 6). На американских однодолларовых банкнотах были найдены представители 397 видов бактерий из 20 филумов, в основном — актинобактерии, фирмикуты и протео-бактерии (рис. 7).


Никакой стройной картины из этих исследований пока не складывается, но это типичное состояние дел для массовых метагеномных исследований: бактериальные сообщества очень разнообразны. Ясно одно: бабушка была права, надо мыть руки после денег. Такой совет содержится в большинстве работ, особенно в тех, где исследовались деньги работников общепита.
М. Г.
1. Abrams B. L., Waterman N. G. Dirty money // JAMA. 1972. 219. P. 1202–1203.
2. Jalali S. et al. Screening currency notes for microbial pathogens and antibiotic resistance genes using a shotgun metagenomic approach // PLoS ONE. 2015. 10:e0128711.
3. Maritz J. M. Filthy lucre: A metagenomic pilot study of microbes found on circulating currency in New York City // PLoS ONE. 2017. 12:e0175527.
4. Okungbowa F. I., Dede A. P. O. Fungal flora of Nigerian currency notes in circulation in Benin City, Nigeria // Indian J. Microbiol. 2010. 50. P. 139–141.
5. Pereira da Fonseca T. A. et al. Molecular analysis of bacterial microbiota on brazilian currency note surfaces // Int. J. Environ. Res. Public Health. 2015. 12. P. 13276–13288.
6. Schaarschmidt J. Upon the occurrence of bacteria and minute algae on the surface of paper money // Nature. 1884. 30. P. 360.
7. Vriesekoop F. et al. Dirty money: an investigation into the hygiene status of some of the world’s currencies as obtained from food outlets // Foodborne Pathog. Dis. 2010. 7. P. 1497–1502.
8. Vriesekoop F. et al. Dirty money: a matter of bacterial survival, adherence, and toxicity // Microorganisms. 2016. 4. P. 42.